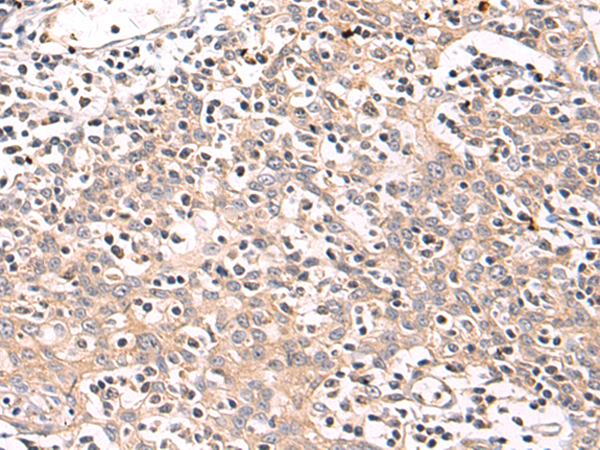
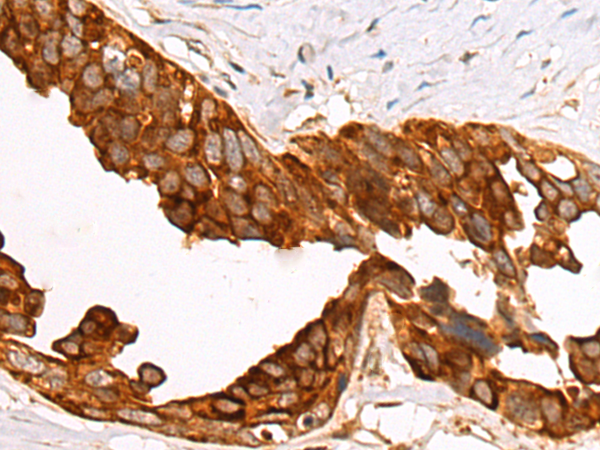

-
分类: 科研抗体货号: P03581别名: MCM; MUT应用: IHC反应种属: Human, Mouse
-
分类: 科研抗体货号: P03579别名: LH3应用: WB,IHC反应种属: Human, Mouse, Rat
-
分类: 科研抗体货号: P03631别名: BNPI; VGLUT1应用: IHC反应种属: Human, Mouse, Rat
-
分类: 科研抗体货号: P03577别名: RHOBP; P76RBE应用: WB,IHC反应种属: Human, Mouse
-
分类: 科研抗体货号: P03651别名: X3; SYG1应用: IHC反应种属: Human, Mouse
-
分类: 科研抗体货号: P03630别名: TDU; VGL1应用: WB反应种属: Human
-
分类: 科研抗体货号: P03642别名:应用: WB反应种属: Human
-
分类: 科研抗体货号: P03648别名: APP1; SAMP; XPNPEP; XPNPEPL; XPNPEPL1应用: WB反应种属: Human, Mouse
-
分类: 科研抗体货号: P03627别名: VRP, Flt4-L应用: WB,IHC反应种属: Human
-
分类: 科研抗体货号: P03641别名: ERP1; Z1971应用: WB反应种属: Human

鄂公网安备42018502007531号
鄂公网安备42018502007531号

